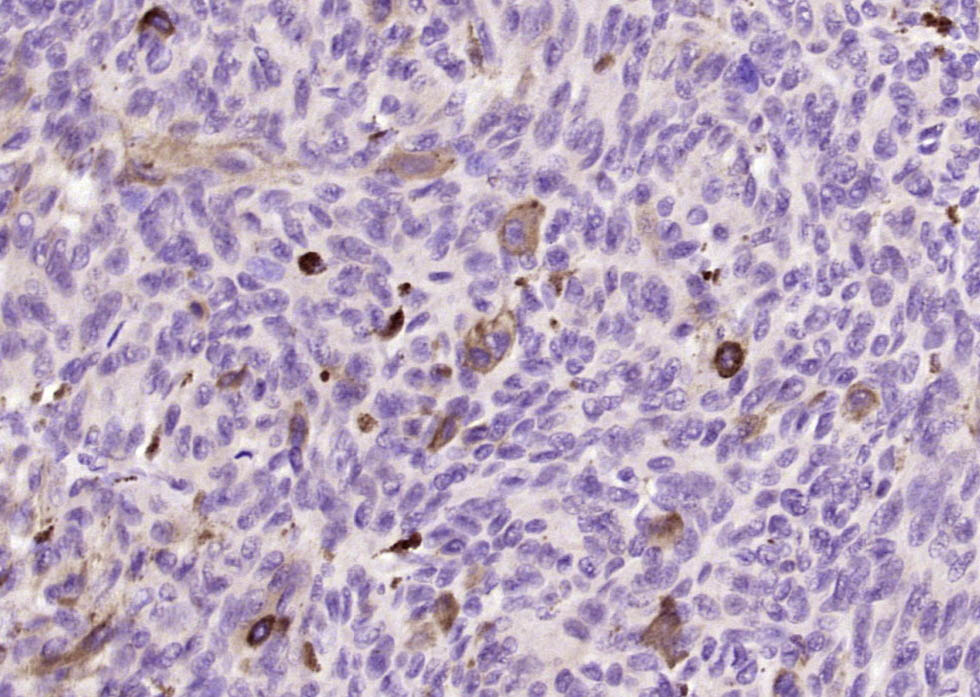
产品细节图片2

相关产品推荐更多 >
万千商家帮你免费找货
0 人在求购买到急需产品
- 详细信息
- 询价记录
- 文献和实验
- 技术资料
- 应用范围:
产品信息以Bioss网站为准
- 规格:
50ul/100ul/200ul
| 规格: | 50ul | 产品价格: | ¥1180.0 |
|---|---|---|---|
| 规格: | 100ul | 产品价格: | ¥1980.0 |
| 规格: | 200ul | 产品价格: | ¥2800.0 |
| 产品编号 | bs-17478R |
| 英文名称 | Melanoma gp100 Rabbit pAb |
| 中文名称 | 黑色素瘤相关抗原gp100抗体 |
| 英文别名 | 95 kDa melanocyte specific secreted glycoprotein; 95 kDa melanocyte-specific secreted glycoprotein; D12S53E; gp100; M-beta; ME20; ME20 M/ME20 S; ME20-M; ME20-S; ME20M; ME20M/ME20S; ME20S; Melanocyte lineage specific antigen GP100; Melanocyte protein mel 17; Melanocyte protein Pmel 17; Melanocyte protein Pmel 17 precursor; Melanocytes lineage-specific antigen GP100; Melanoma associated ME20 antigen; Melanoma gp100; Melanoma-associated ME20 antigen; Melanosomal matrix protein 17; Melanosomal matrix protein17; P1; p100; p26; PMEL 17; PMEL; PMEL_HUMAN; PMEL17; Premelanosome protein; Secreted melanoma-associated ME20 antigen; SI; SIL; SILV; Silver(mouse homolog) like; Silver homolog; Silver locus protein homolog; Silver, mouse, homolog of. |
| 产品应用 | WB=1:500-2000, IHC-P=1:100-500, IHC-F=1:100-500, IF=1:100-500 Not yet tested in other applications. |
| 交叉反应 | Human (Horse) |
| 抗体来源 | Rabbit |
| 免疫原 | KLH conjugated synthetic peptide derived from human Melanoma gp100 |
| 亚型 | IgG |
| 性状 | Liquid |
| 纯化方法 | affinity purified by Protein A |
| 克隆类型 | Polyclonal |
| 理论分子量 | 68 kDa |
| 浓度 | 1mg/ml |
| 储存液 | 0.01M TBS (pH7.4) with 1% BSA, 0.02% Proclin300 and 50% Glycerol. |
| 研究领域 | Cancer > Tumor immunology > Tumor-associated antigens Metabolism > Pathways and Processes > Metabolic signaling pathways > Amino acid metabolism Signal Transduction > Metabolism > Amino Acids Tags & Cell Markers > Cell Type Markers > Tumor Associated |
| 亚细胞定位 | Secreted and Endoplasmic reticulum membrane. Golgi apparatus. Melanosome. Endosome > multivesicular body. Identified by mass spectrometry in melanosome fractions from stage I to stage IV. Localizes predominantly to intralumenal vesicles (ILVs) within multivesicular bodies. Associates with ILVs found within the lumen of premelanosomes and melanosomes and particularly in compartments that serve as precursors to the striated stage II premelanosomes.Target information above from: UniProt accession P40967 The UniProt Consortium The Universal Protein Resource (UniProt) in 2010 Nucleic Acids Res. 38:D142-D148 (2010) . |
| 组织特异性 | Preferentially expressed in melanomas. Some expression was found in dysplastic nevi. Not found in normal tissues nor in carcinomas. Normally expressed at low levels in quiescent adult melanocytes but overexpressed by proliferating neonatal melanocytes and during tumor growth. |
| 翻译后修饰 | A small amount of P1/P100 (major form) undergoes glycosylation to yield P2/P120 (minor form). P2 is cleaved by a furin-like proprotein convertase (PC) in a pH-dependent manner in a post-Golgi, prelysosomal compartment into two disulfide-linked subunits: a large lumenal subunit, M-alpha/ME20-S, and an integral membrane subunit, M-beta. Despite cleavage, only a small fraction of M-alpha is secreted, whereas most M-alpha and M-beta remain associated with each other intracellularly. M-alpha is further processed to M-alpha N and M-alpha C. M-alpha C further undergoes processing to yield M-alpha C1 and M-alpha C3 (M-alpha C2 in the case of PMEL17-is or PMEL17-ls). Formation of intralumenal fibrils in the melanosomes requires the formation of M-alpha that becomes incorporated into the fibrils. Stage II melanosomes harbor only Golgi-modified Pmel17 fragments that are derived from M-alpha and that bear sialylated O-linked oligosaccharides. N-glycosylated. O-glycosylated; contains sialic acid. |
| 相似性 | Belongs to the PMEL/NMB family. Contains 1 PKD domain. |
| 功能 | Plays a central role in the biogenesis of melanosomes. Involved in the maturation of melanosomes from stage I to II. The transition from stage I melanosomes to stage II melanosomes involves an elongation of the vesicle, and the appearance within of distinct fibrillar structures. Release of the soluble form, ME20-S, could protect tumor cells from antibody mediated immunity. |
| 保存条件 | Shipped at 4℃. Store at -20℃ for one year. Avoid repeated freeze/thaw cycles. |
| 注意事项 | This product as supplied is intended for research use only, not for use in human, therapeutic or diagnostic applications. |
| 背景资料 | This gene encodes a melanocyte-specific type I transmembrane glycoprotein. The encoded protein is enriched in melanosomes, which are the melanin-producing organelles in melanocytes, and plays an essential role in the structural organization of premelanosomes. This protein is involved in generating internal matrix fibers that define the transition from Stage I to Stage II melanosomes. This protein undergoes a complex pattern of prosttranslational processing and modification that is essential to the proper functioning of the protein. A secreted form of this protein that is released by proteolytic ectodomain shedding may be used as a melanoma-specific serum marker. Alternate splicing results in multiple transcript variants. [provided by RefSeq, Jan 2011] |
| 应用 | 推荐稀释比例 |
| {WB} | {1:500-2000} |
| {IHC-P} | {1:100-500} |
| {IHC-F} | {1:100-500} |
| {IF} | {1:100-500} |

U251(Human) Cell Lysate at 30 ug
ASPC-1(Human) Cell Lysate at 30 ug
MDA-MB-231(Human) Cell Lysate at 30 ug
Primary: Anti- Melanoma gp100 (bs-17478R) at 1/1000 dilution
Secondary: IRDye800CW Goat Anti-Rabbit IgG at 1/20000 dilution
Predicted band size: 68 kD
Observed band size: 62 kD
风险提示:丁香通仅作为第三方平台,为商家信息发布提供平台空间。用户咨询产品时请注意保护个人信息及财产安全,合理判断,谨慎选购商品,商家和用户对交易行为负责。对于医疗器械类产品,请先查证核实企业经营资质和医疗器械产品注册证情况。
- 作者
- 内容
- 询问日期
文献和实验[IF={{ 8.786 }}] {Zhang Yushan. et al. Establishment and validation of evaluation models for post-inflammatory pigmentation abnormalities. FRONT IMMUNOL. 2022 Oct;0:6492} {WB} {Human}
NRK 肾细胞L-6TG 肌母细胞 3.仓鼠类BHK 幼仓鼠肾V79 中国仓鼠肺细胞CHL 中国仓鼠肺细胞CHO 中国仓鼠卵巢细胞R1610 中国仓鼠体细胞*CHO/dhFr- 二氢叶酸还原酶缺陷型CHO4.人类 2BS 胚肺 XJH B淋巴细胞 HLF 胚肺 L-02 肝细胞 WI-38 胚肺 Chang Liver 张氏肝 SL-7 胚肺 QSG-7701 肝细胞 H.A. 羊膜 293 Ad5DNA转化的胚肾 WISH 羊膜
GE Healthcare Benzamidine Sepharose™ 6B is p-aminobenzamidine covalently attached to Sepharose 6B by the epoxy coupling method. p-Aminobenzamidine (PAB), is a synthetic inhibitor of trypsin-like serine protease. Trypsin and trypsin
Immunohistochemistry / Immunocytochemistry Procedures
). Rabbit anti-Indolamine 2, 3-dioxygenase (Cat. No. AB5968 ) staining of a lymph node from a human patient with malignant melanoma
技术资料暂无技术资料 索取技术资料







